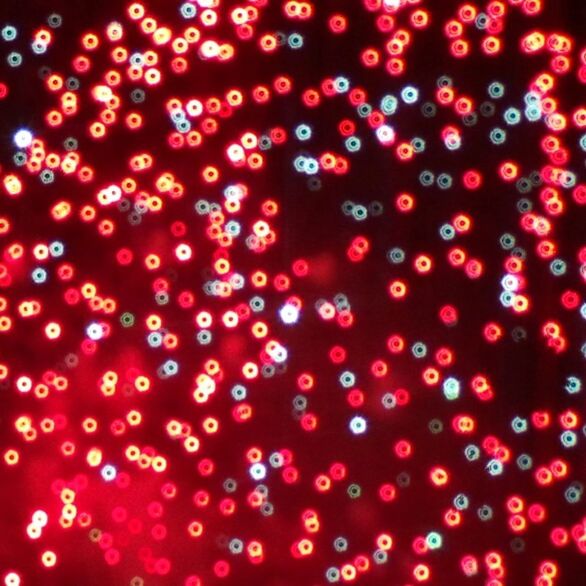

Get every image at 80% off with our flexible subscriptions. Buy for less.

Premium
$ 99.00
All Basic licenses are royalty-free and include commercial use across all media and 500,000 print publications. Learn more
Need more usage rights or something tailored to your budget?
Get a customized deal